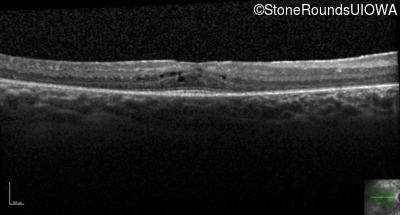
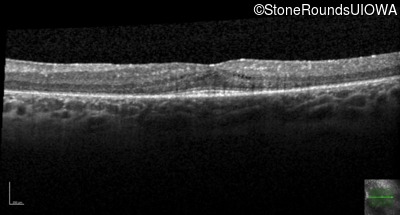
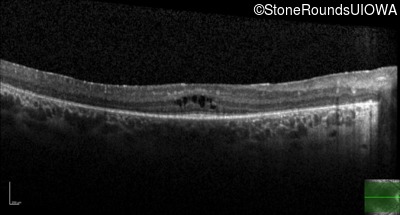
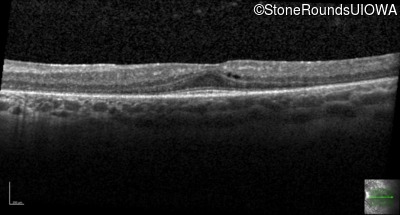
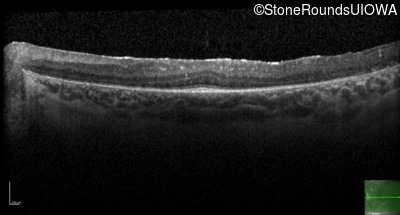

Case
SR465
Student Mode
ECORD (IA2c)
Female
Female
Hidden
SR465
Student Mode
ECORD (IA2c)
Female
Female
History
The parents of this 24 year old woman first noticed that she had poor peripheral vision when she was two years of age. She also had difficulty seeing in dim light.
| Age at visit: 24 years |
| Age at visit: 25 years |
| OD | OS | ||
|---|---|---|---|
| OD | OS | ||
|---|---|---|---|
| Age at visit: 27 years |
| OD | OS | ||
|---|---|---|---|
| OD | OS | ||
|---|---|---|---|